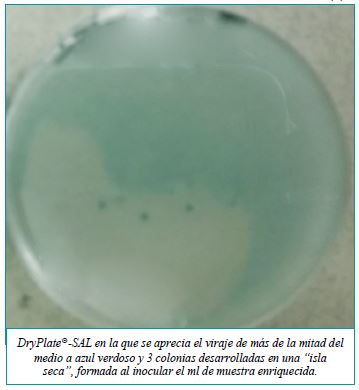
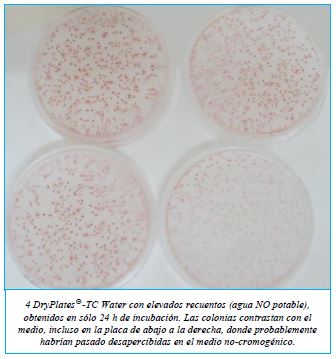
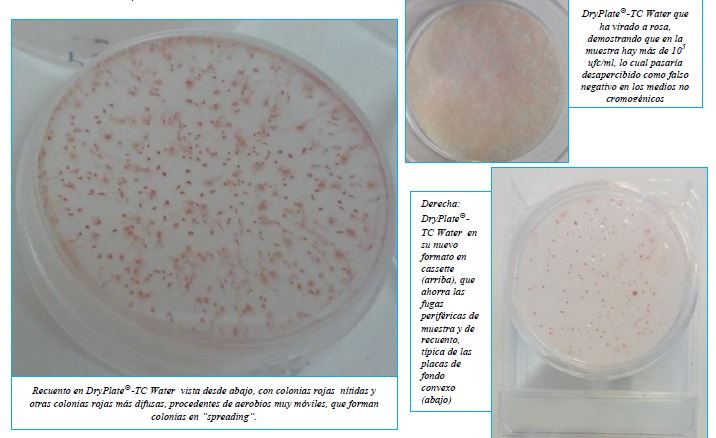
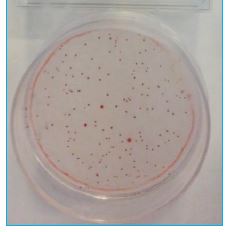

DryPlates-ETC
DryPlates-Enterococos para la detección y recuento de enterococos fecales en 1 mL de muestra en alimentos y otros productos
Placas preparadas de medio deshidratado en disco nutriente, estériles y listas para su uso inmediato,
que se hidratan precisamente mediante la muestra en el momento de inocularla en frío,
lo que ahorra el hervido-fusión-enfriado-a-45ºC y las 2 horas de todo este trabajo propio del medio clásico para siembra por inclusión en masa.
Extraordinariamente alta caducidad: 1 año desde fabricación.

Bilis Esculina Azida es el Agar confirmativo oficial (ISO7899),
donde los Enterococos fecales crecen con colonias negras o marrones en sólo 18h.
Raramente otros microorganismos pueden crecer en este medio, pero en tal caso lo hacen con colonias de otros colores.
El medio es válido para muestras de aguas, alimentos, cosméticos, ambientes…
Ver también las DryPlates® del otro medio oficial (Slanetz-Bartley Agar), aunque tarda mucho más en obtener resultados (48h en vez de 18h).
MODO DE EMPLEO para muestras de 1 ml
- Con unas pinzas, sacar un disco nutriente de su bolsa y colocar en la tapa de una placa DryPlates® recién abierta.
- Colocar la placa en una superficie horizontal, sin inclinaciones. Añadir al centro de la base de la placa 1 ml de la muestra líquida (si es espesa, realice diluciones decimales hasta que sea acuosa), bien centrada (mejor que la muestra no toque las paredes internas de la placa, para que la autodifusión sea mucho más rápida y homogénea)
- Voltear la tapa con disco nutriente para volver a cerrar la placa, con cuidado para que el disco nutriente caiga centrado sobre la muestra; de este modo se repartirá homogéneamente en un instante. Con un poco de práctica le saldrá perfecto.
- Si lo prefiere, puede tomar el disco nutriente con unas pinzas y colocarlo directamente sobre el ml de muestra, previamente dispensado en el centro de la placa). No añada la muestra sobre el disco nutriente, ya que no difundirá homogéneamente y tardará mucho en hacerlo.
-
NOTA
- La formación de “islas secas” sin muestra, sólo debe preocupar si éstas son muy grandes, ya que al incubar desaparecerán y además el número de colonias por placa en 1 ml de muestra será el mismo con o sin ellas (aunque haya calvas sin colonias y el reparto sea heterogéneo).
- Incubar en estufa, IMPORTANTE: en atmósfera húmeda (dejar un vaso de agua siempre lleno en cada esquina de la estufa, total 4 vasos), sin voltear las placas (el disco abajo) para que no se fugue parte de muestra durante la incubación.
- Nunca incube las DryPlates® directamente sobre la bandeja de la estufa, intercale dos placas vacías (como“base porta-placas” para poner entre la torre de placas y la base metálica de la estufa) para que la DryPlate® no se seque durante la incubación por el exceso de calor del metal; igualmente no deje que la torre de placas toque la paredes de la estufa.
- Si va en placa redonda y no en cassette, lo ideal para prevenir su desecación es meter cada DryPlate® sembrada, en una bolsa autosellable y cerrarla muy bien. Las condiciones de incubación (tiempo y temperatura) son las estándar: 35-37ºC durante 18-24h. Antes de leer, es muy importante verificar que la superficie de la placa sigue húmeda.
-
INTERPRETACIÓN DE RESULTADOS para muestras de 1 ml
- Leer los resultados buscando sólo las colonias diana: Enterococos fecales, colonias marrones, ocre o negras.
- Las DryPlates® ETC obtienen una recuperación de enterococos fecales muy superior respecto a los medios similares agarizados en placa clásica (incluido Slanetz-Bartley Agar, Bilis Esculina Azida Agar, Medio cromogénico para Enterococos fecales y KAA Agar).
MODO DE EMPLEO para muestras líquidas filtradas (100, 250… ml)
Siga los mismos pasos que en el caso anterior pero con las siguientes salvedades:Prehidrate el disco nutriente en la placa con 1 ml de agua estéril (o de la misma agua de muestra). Recuerde, siempre el disco sobre el agua centrada y nunca el agua sobre el disco nutritivo.
Filtrar la muestra líquida (100, 250… ml) por una membrana estéril de 0,45 μm y depositar la membrana sobre el disco prehidratado de la DryPlates® ETC.
Enterococos fecales, colonias marrones en Dryplates®-ETC
Si pre-hidrató el disco con 1 ml de agua de muestra (en vez de agua estéril) y filtró por ejemplo 100 ml, su recuento será en tal caso en 101 ml, aunque este 1% en microbiología es irrelevante.
También puede resembrar la membrana con colonias rojas, procedente de DryPlates® SB
MODO DE EMPLEO para ambientes interiores (superficies y aires) y para detección de patógenos tras enriquecimiento
Puede estriar un escobillón con el que haya barrido una muestra de superficies, o con un asa con caldo enriquecido, sobre cualquier DryPlates®, previamente hidratada con 1 ml de agua estéril (recuerde, el disco sobre el ml de agua centrado y no al revés).
El viraje de la estría y las colonias aisladas al final de la misma contrastarán mejor con el color de base del medio.
También puede dejar la DryPlates® de cualquier medio, previamente hidratada con 1 ml de agua estéril (recuerde, el disco sobre el agua y nunca el agua sobre el disco nutritivo), abierta durante 10-15 minutos en los puntos críticos de la sala,
para realizar una estimación “de campo” de la flora ambiental (aunque es mejor usar un muestreador tipo Microflow o MBS para obtener recuentos por m3 de aire)
CONSERVACIÓN Y PRECAUCIONES DE USO
Almacenar a temperatura ambiente (ideal 15-25ºC) ¡no en nevera!, ya que en ésta la humedad es más fácil que prehidrate y estropee los discos nutrientes.
Eso sí, es imprescindible almacenar en lugar muy seco y oscuro, ya que la humedad y la luz dañan irreversiblemente los medios de cultivo deshidratados.
Si trabaja en zonas de alta humedad atmosférica, almacene las DryPlates®, bien cerradas en su bolsa, dentro de una caja hermética “tupper” con sacos antihumedad (ej: MICROKIT VRB747).
Otros muchos medios en DryPlates®:
Aerobios totales (medios diferentes en alimentos, en cosméticos, en aguas, en aguas oligotróficas, en medicamentos, en bebidas alcohólicas),
Levaduras y Mohos (en alimentos, en cosméticos, en aguas, en medicamentos),
Enterobacterias (VRBG o cromogénico),
Coliformes y E.coli,
E.coli,
Staphylococcus aureus,
Bacillus cereus,
Pseudomonas aeruginosa,
Burkholderia cepacia,
Candida albicans,
Enterococos fecales (SB ó BEA a elegir),
Salmonella spp. (Cromosalm y XLD),
Vibrio parahaemolyticus-Vibrio cholerae,
Antiobiograma cromogénico, UTIs…
Si necesita otros medios en formato DryPlates® podemos diseñarlos especialmente para Ud.
El usuario final es el único responsable de la eliminación de los microorganismos según la legislación medioambiental vigente. Autoclavar antes de desechar a la basura. Diseño y fabricación 100% españoles.

https://www.microkit.es/fichas/Dry-Plates-ETC-Prospecto.pdf
Ver tambien DryPlates-SB:
https://www.microkit.es/fichas/Dry-Plates-Slanetz-Bartley-Prospecto.pdf
https://www.microkit.es/monograficos/16-Enterococos-fecales-monograf–a.pdf
Haga sus consultas de este medio en: microkit@microkit.es
Haga sus pedidos de este medio en: pedidos@microkit.es
En este vídeo puedes entender mejor la hazaña de las DryPlates® y cómo usarlas: